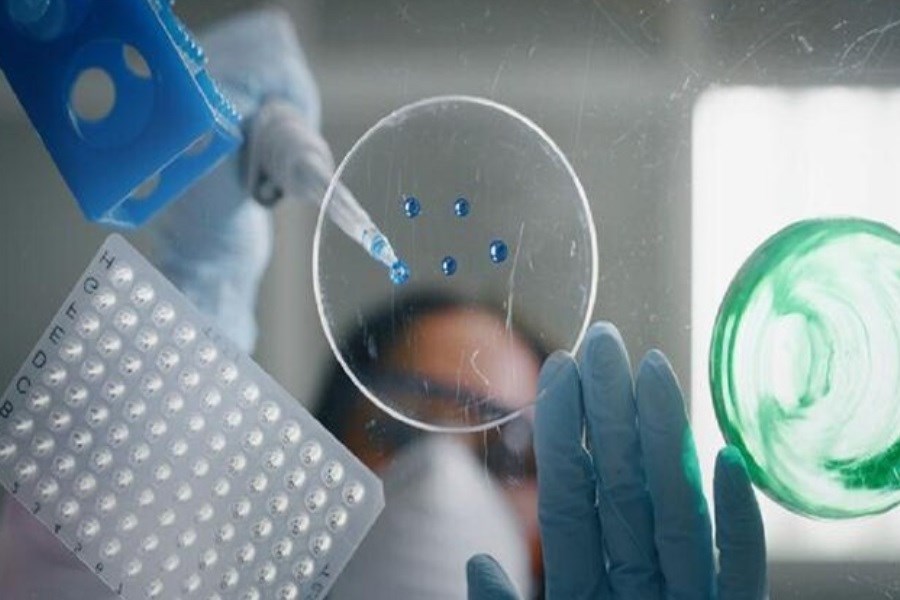

به گزارش سایت خبری پُرسون، پژوهشگران دانشگاه کیس وسترن رزرو با بهرهگیری از نانوحبابهای حاوی گاز بیاثر و تحریک آنها با امواج فراصوت، موفق شدند سد سخت و نفوذناپذیر تومورهای جامد را تضعیف کنند؛ رویکردی نوآورانه که میتواند اثربخشی ایمنیدرمانیهای نوین را بهطور چشمگیری افزایش دهد و راه را برای ورود سریعتر به کارآزماییهای بالینی هموار کند. این گروه تحقیقاتی در دانشگاه کیس وسترن رزرو (Case Western Reserve University) نتایج کار خود را در نشریه معتبر ACS Nano منتشر کرده است.
پژوهشگران با تزریق نانوحبابهای حاوی گاز بیاثر به درون تومور و سپس لرزاندن آنها با امواج فراصوت توانستند ساختار سخت و فشرده تومور را بدون تخریب گسترده سلولها تضعیف کنند. این فرایند، مسیر را برای نفوذ مولکولهای درمانی و سلولهای ایمنی به درون بافت سرطانی هموار میکند.
افتستاتیوس کاراتاناسیس، استاد و نایبرئیس مهندسی زیستپزشکی که در دانشکده مهندسی کیس و دانشکده پزشکی این دانشگاه فعالیت دارد، اعلام کرد سد فیزیکی تومورها یکی از عوامل اصلی محدودکننده رسانش داروهای ضدسرطان بهویژه ایمنیدرمانیهای نوین به شمار میرود. به گفته او، راهبرد تازه مبتنی بر نانوحبابهای فعالشونده با فراصوت، ریزمحیط تومور را بهآرامی بازآرایی کرده و عملاً دیوارههای دفاعی آن را فرو میریزد تا راه برای ورود داروها و سلولهای ایمنی گشوده شود.
نکته امیدبخش آن است که این فناوری میتواند با سرعت بیشتری به مرحله آزمون بالینی برسد؛ زیرا نانوحبابهای طراحیشده پیشتر برای شناسایی سرطان پروستات در مسیر تجاریسازی قرار گرفتهاند و دستگاههای فراصوت نیز مورد تأیید سازمان غذا و داروی آمریکا (Food and Drug Administration) هستند و بهطور گسترده در مراکز درمانی استفاده میشوند.
در روند رشد تومورها، بافتی غیرعادی، سخت و متراکم پیرامون آنها شکل میگیرد که عمدتاً از کلاژن ــ پروتئینی که در تشکیل بافتهای اسکار نقش دارد ــ ساخته شده است. این لایه متراکم، مانع نفوذ درمانهای ایمنی مدرن بهویژه ریبونوکلئیک اسید (Ribonucleic Acid) یا همان آرانای که درون نانوذرات لیپیدی حمل میشود، به سلولهای ایمنی مستقر در تومور میشود.
پژوهشگران در یک الگوی سرطان پستان، نانوحبابهایی حاوی گاز پرفلوئوروپروپان را به درون تومور تزریق کردند. سپس با هدایت امواج فراصوت به محل تومور، این حبابهای میکروسکوپی را به لرزش درآوردند. این لرزش کنترلشده، ساختار سخت تومور را درهم شکست، بیآنکه تخریب وسیع سلولی ایجاد کند.
این طرح حاصل همکاری آزمایشگاه نانوفناوری و ایمنیدرمانی کاراتاناسیس با آزمایشگاه فراصوت و نانودارو متعلق به آگاتا اگزنر، استاد رادیولوژی و مدیر مرکز پژوهشهای تصویربرداری این دانشگاه بود. یافتهها نشان داد پس از این مداخله، تومورها نرمتر، یکنواختتر و برای نفوذ سلولهای ایمنی و نانوذرات، پذیراتر شدند.
اگزنر تأکید کرد که این تیم داروی تازهای ابداع نکرده، بلکه راهی یافته است تا اثربخشی درمانهای موجود و در حال توسعه بهمراتب افزایش یابد. به بیان او، با فروریختن سد دفاعی سرطان، فرصت عادلانهتری برای پیروزی درمانها فراهم میشود.
دستاورد دیگر این پژوهش، فعالسازی سلولهای ایمنی موجود درون تومور حتی بدون افزودن درمان مکمل بود. به گفته کاراتاناسیس، این سلولها پس از مداخله، سیگنالهای هشدار ترشح کرده و سلولهای ایمنی بیشتری را به محل تومور فراخواندند. افزون بر آن، سلولهای تی کشنده که سرطان را هدف قرار میدهند، توانستند سایر تومورها ــ حتی آنهایی که مستقیماً تحت درمان قرار نگرفته بودند ــ را نیز شناسایی و تعقیب کنند.
بررسیها نشان داد تومورهای تحت درمان دستکم تا پنج روز نرمتر باقی ماندند، در حالیکه تومورهای درماننشده بهتدریج سختتر و مقاومتر شدند. هنگامی که پژوهشگران در مرحله بعد، نانوذرات لیپیدی حاوی آرانای تقویتکننده فعالیت سلولهای تی را تزریق کردند، این ترکیبات در سراسر تومور پخش شد و برخلاف گذشته، در محل تزریق محبوس نماند.
به گفته اگزنر، هر توموری که امکان نمونهبرداری از آن وجود داشته باشد، بالقوه میتواند پذیرای نانوحبابها باشد. این موضوع برای تومورهای جامدی که درمان آنها دشوار است و در آنها از فراصوت استفاده میشود ــ مانند سرطانهای کبد، پروستات و تخمدان ــ اهمیت ویژهای دارد.
نانوحبابهای توسعهیافته در آزمایشگاه اگزنر، هماکنون از سوی شرکت ویسانو ترانواستیکس (Visano Theranostics) که او یکی از بنیانگذاران آن است، برای تشخیص سرطان پروستات در مسیر تجاریسازی قرار گرفتهاند. بر اساس اعلام این تیم، درخواست مجوز داروی پژوهشی جدید طی ۱۸ ماه آینده به سازمان غذا و داروی آمریکا ارائه خواهد شد و کاربرد درمانی این فناوری نیز میتواند همزمان با همان پرونده، مسیر ورود به کارآزمایی بالینی را طی کند؛ مسیری که احتمال دارد ظرف دو سال آینده به آغاز آزمونهای انسانی بینجامد.
این دستاورد، تصویری تازه از نبرد با سرطان ترسیم میکند: بهجای تمرکز صرف بر ساخت داروهای جدید میتوان با هوشمندسازی محیط تومور و شکستن حصارهای دفاعی آن، اثربخشی درمانهای موجود را چندبرابر کرد.
منبع: ایسنا